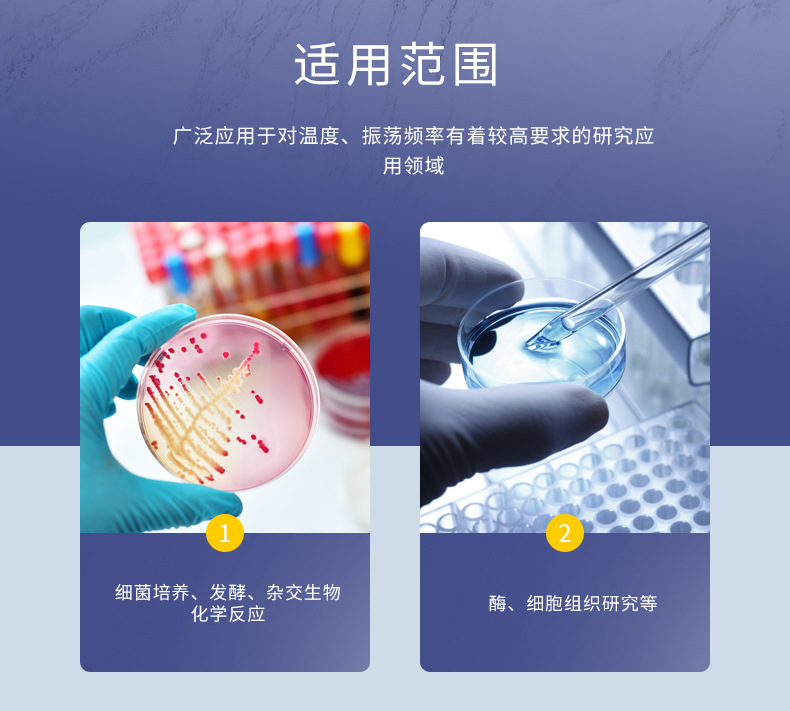
TM轨道式摇床 02.jpg

Индивидуальный Цифровой Дисплей Скорость Регулируемый 3D Ротационный Осциллятор Настольный Постоянная Скорость Осциллятор Лабораторный Tm Серия Орбитальный Шейкер
Цена
¥1035.00 / ≈ 13 152 ₽
MOQ: 1 pcs
1шт - ¥1035.00
Продавец
常州金坛良友仪器有限公司
Рейтинг
5
Продано
1
Всего
В наличии
0
SKU суммарно
Offer ID: 763645355837
Оформить заказ
Спецификация:
| Изображение | Спецификация | Цена (CNY / RUB) | В наличии | SKU ID | Кол-во / Корзина |
|---|---|---|---|---|---|
📦 | Tmx-040pro with stick clamp tray reciprocating type | ¥1035.0 / ≈ 13 152 ₽ | 0 | 5712225938312 | |
📦 | Tmx-040pro with flat tray reciprocating type | ¥1035.0 / ≈ 13 152 ₽ | 0 | 5712225938313 | |
📦 | Tmx-040pro equipped with universal tendon clamp reciprocating type | ¥1280.0 / ≈ 16 265 ₽ | 0 | 5712225938314 | |
📦 | Tm-050pro with stick clip tray rotary type | ¥1500.0 / ≈ 19 061 ₽ | 0 | 5712225938320 | |
📦 | Tm-050pro with flat tray rotary type | ¥1500.0 / ≈ 19 061 ₽ | 0 | 5712225938315 | |
📦 | Tm-050pro equipped with universal beef tendon clamp rotary type | ¥1760.0 / ≈ 22 365 ₽ | 0 | 5712225938316 | |
📦 | Tmx-050pro with stick clip tray reciprocating type | ¥1500.0 / ≈ 19 061 ₽ | 0 | 5712225938317 | |
📦 | Tmx-050pro with flatbed tray reciprocating type | ¥1500.0 / ≈ 19 061 ₽ | 0 | 5712225938318 | |
📦 | Tmx-050pro equipped with universal tendon clamp reciprocating type | ¥1760.0 / ≈ 22 365 ₽ | 0 | 5712225938319 | |
📦 | Price grids include regular tickets, special tickets require an additional 12 points | ¥1760.0 / ≈ 22 365 ₽ | 0 | 5766596207083 |
Статистика продавца
4.0
Сервис
Источник: API 1688
2.5
Логистика
Источник: API 1688
5.0
Споры
Источник: API 1688
5.0
Оформление
Источник: API 1688
3.0
Консультация
Источник: API 1688
52%
Повторные покупки
Источник: API 1688
5.0
Постпродажное
Источник: API 1688
Свойства товара
Место происхождения Changzhou city, jiangsu province
Импортный: Да/Нет No
Номер заказа No
Амплитуда колебаний 20mm
Код продукта No
Размер See details
Диапазон времени 1min~99h59min
Обработка и настройка No
Тип Shaker
Бренд Jtliangyou
Объем See details
Диапазон контроля температуры See details
Модель Tm series
Частота вращения 40 ~ 350 rpm
Вес See details
Будет ли поставка товаров исключительно для трансграничного экспорта No
Описание товара
|
|